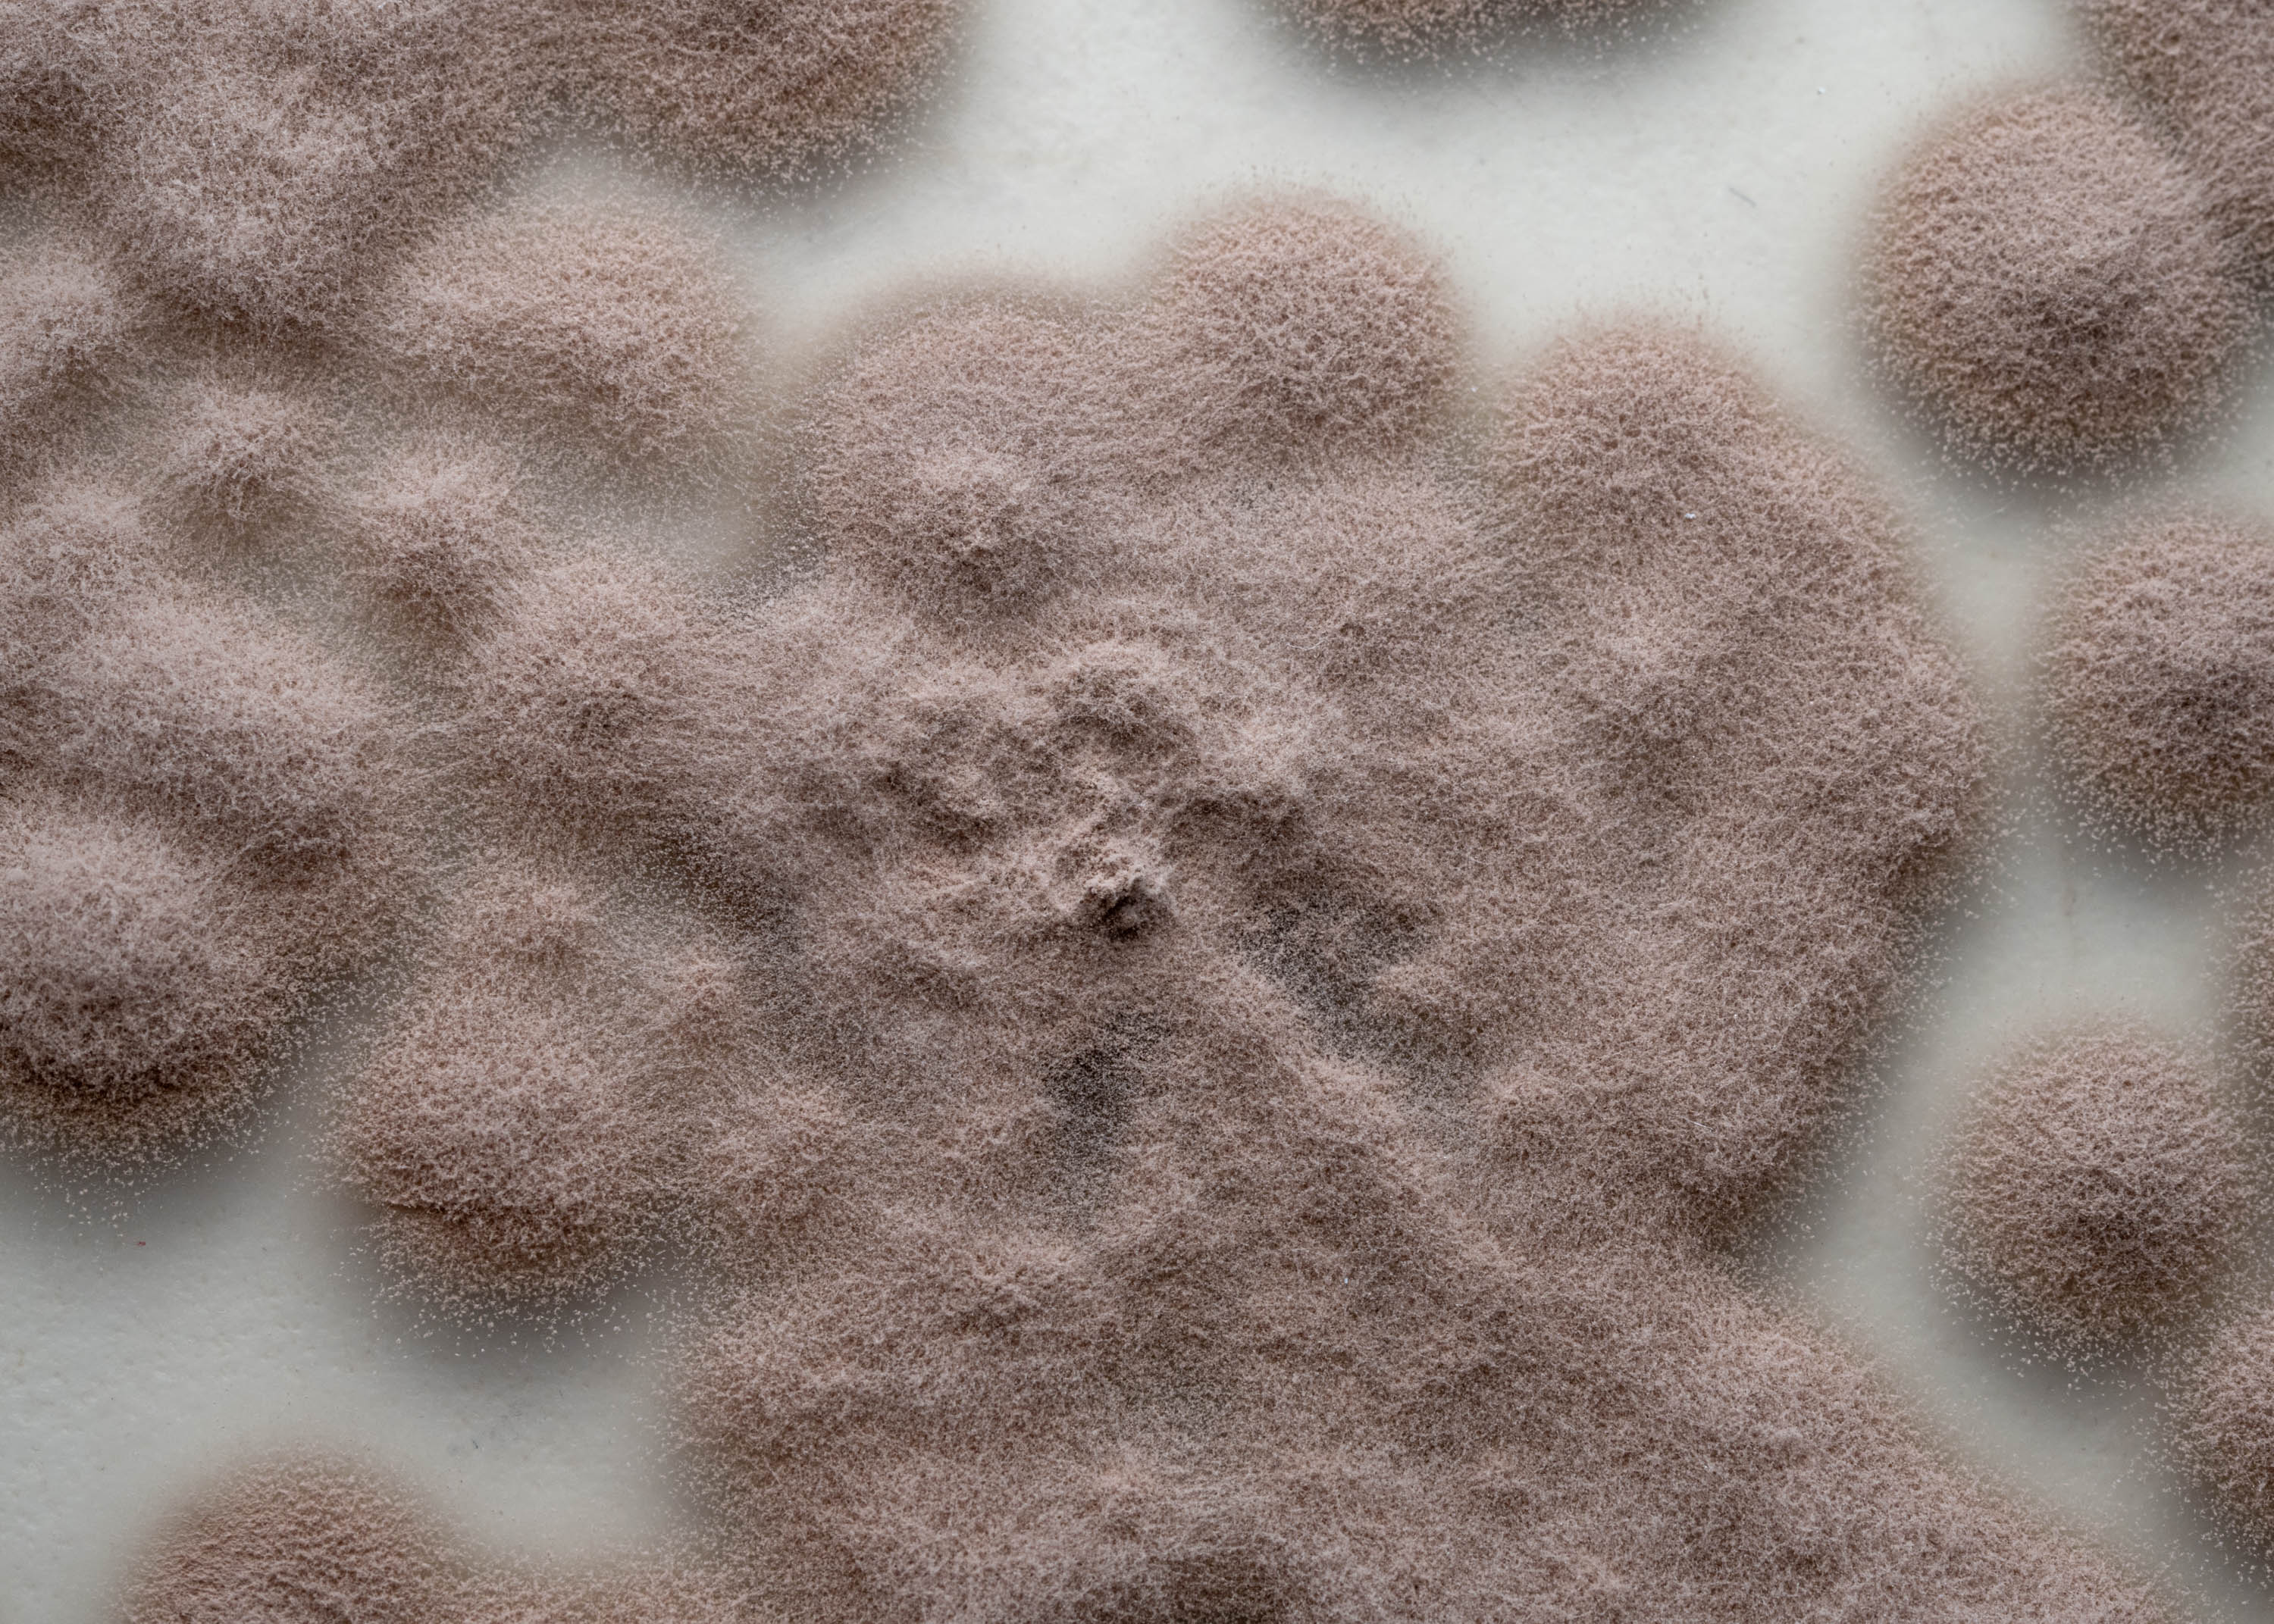
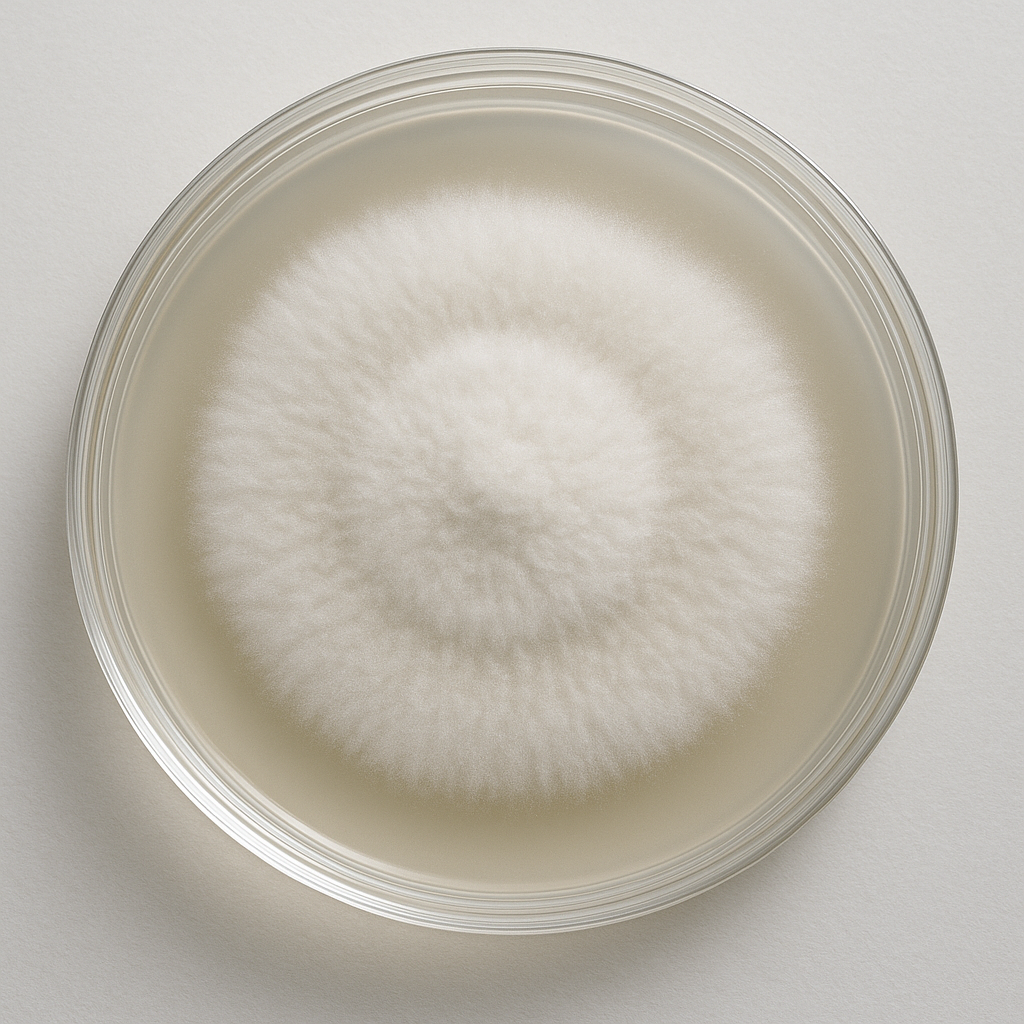
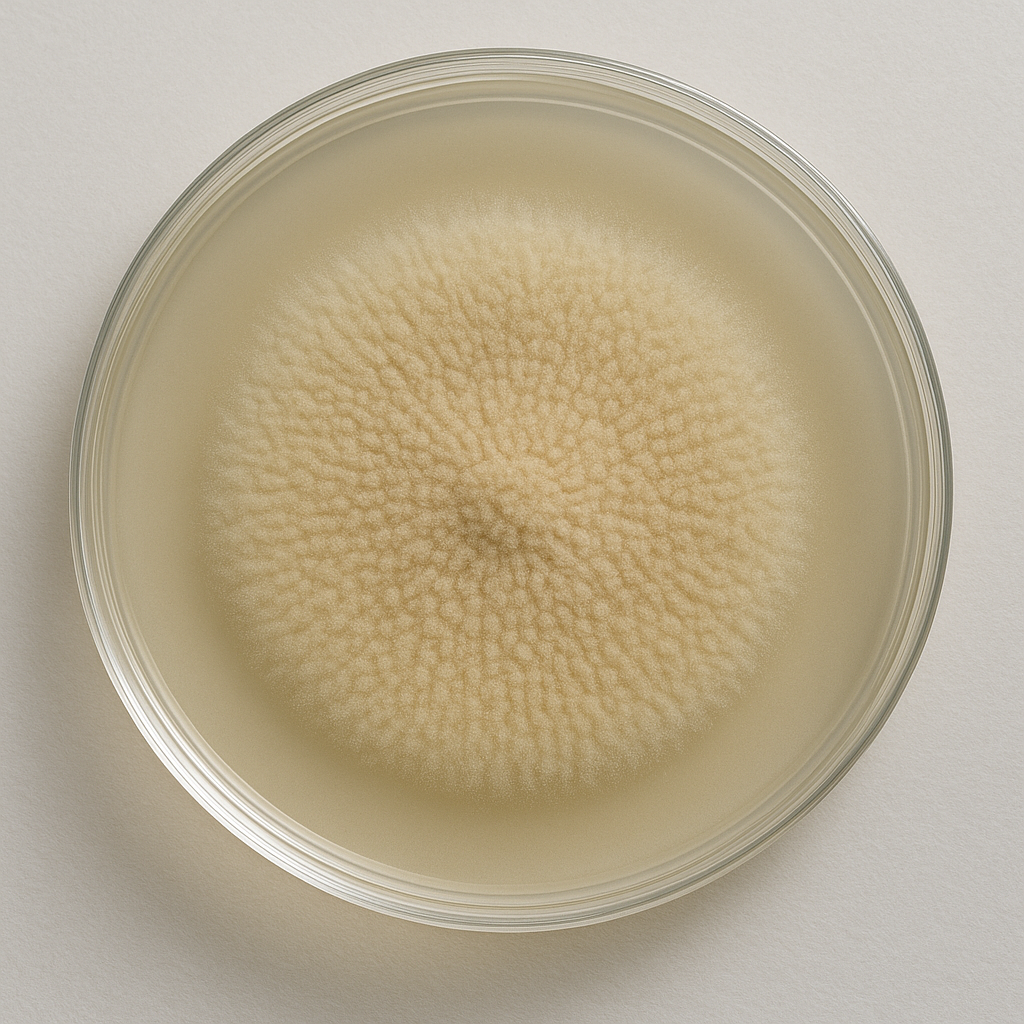
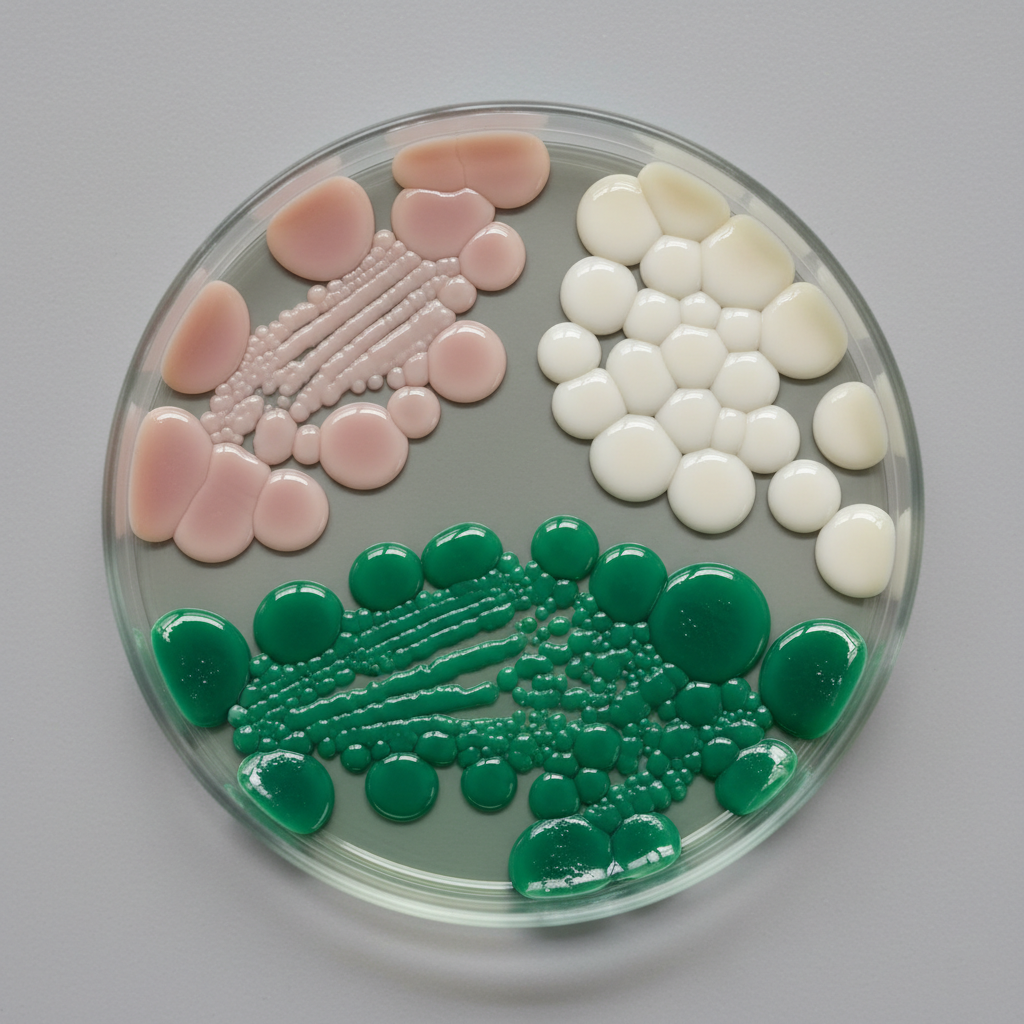

Catálogo de Productos
Soluciones biotecnológicas avanzadas para agricultura regenerativa y sostenible
Biofertilizantes
Formulaciones biotecnológicas avanzadas para optimizar la fertilidad del suelo y potenciar el desarrollo vegetal

Star Dust
Carbón vegetal activado con tecnología de pirolisis avanzada, enriquecido con consorcios microbianos específicos. Incrementa la capacidad de intercambio catiónico del suelo, mejora la retención hídrica y establece una base sólida para el ecosistema radicular. Su estructura porosa actúa como refugio para microorganismos beneficiosos, optimizando los ciclos biogeoquímicos y la disponibilidad de nutrientes.

Tricochar
Matriz de carbón bioactivado inoculado con cepas seleccionadas de Trichoderma harzianum. Esta sinergia biotecnológica proporciona control biológico preventivo contra patógenos radiculares, mientras que el biochar mejora las propiedades físico-químicas del sustrato. Estimula la formación de micorrizas y incrementa la eficiencia en la absorción de fósforo y micronutrientes.

Biochar Blend
Formulación integral que combina carbón vegetal activado, materia orgánica compostada y consorcios microbiológicos multifuncionales. Aporta macro y micronutrientes de liberación controlada, mejora la estructura del suelo aumentando la porosidad y estabilidad de agregados. Facilita la colonización de rizobacterias promotoras del crecimiento vegetal (PGPR) y optimiza los procesos de mineralización.
Biocontroladores
Agentes de control biológico especializados para el manejo integrado de plagas y enfermedades

Trichoderma Harzianum
Cepa élite de hongo filamentoso con actividad micoparasítica demostrada contra Fusarium, Rhizoctonia, Sclerotinia y Pythium. Produce metabolitos antifúngicos específicos, enzimas quitinolíticas y establece competencia por espacio y nutrientes. Su colonización radicular induce resistencia sistémica adquirida (SAR), mejorando las defensas naturales de la planta y optimizando la absorción de nutrientes.

Metarhizium Anisopliae
Hongo entomopatógeno especializado en el control biológico de coleópteros, hemípteros, lepidópteros y dípteros. Su mecanismo de acción incluye adhesión al tegumento del insecto, penetración cuticular mediante enzimas proteolíticas y colonización hemocélica. Presenta alta especificidad hacia plagas sin afectar insectos benéficos, manteniendo el equilibrio del agroecosistema.
Purpureocillium lilacinum
Agente de biocontrol altamente eficaz contra nematodos fitopatógenos incluyendo Meloidogyne, Heterodera, Globodera y Pratylenchus. Su modo de acción involucra la parasitación de huevos mediante enzimas quitinasas y proteasas, destruyendo las masas ovígeras y reduciendo significativamente las poblaciones. Mejora la salud radicular y promueve el desarrollo de sistemas radicales robustos.
Beauveria Bassiana
Hongo entomopatógeno de amplio espectro especializado en el control de hemípteros, tisanópteros, afídidos y ácaros fitófagos. Su infección procede por contacto directo, germinación de conidias sobre la cutícula y penetración mediante apresorio. Produce toxinas específicas como bassianolidas que causan disfunción fisiológica en el hospedero, resultando en mortalidad efectiva y sostenida.
Bacillus thuringiensis
Bacteria Gram-positiva productora de cristales proteicos (δ-endotoxinas) con actividad insecticida específica contra larvas de lepidópteros. Sus proteínas Cry se activan en el pH alcalino del intestino medio larvario, causando lisis celular y parálisis del sistema digestivo. Altamente selectivo, no afecta organismos no objetivo y es completamente biodegradable en el ambiente.
SiriusBacter
Consorcio de rizobacterias promotoras del crecimiento vegetal (PGPR) que incluye cepas de Bacillus, Pseudomonas y Azotobacter. Facilita la solubilización de fosfatos, fijación biológica de nitrógeno y producción de fitohormonas (auxinas, giberelinas, citoquininas). Induce resistencia sistémica inducida (ISR) mediante la activación de rutas de señalización de defensa, optimizando la respuesta ante estrés biótico y abiótico.
Carrito de Cotización
Revisa y ajusta tu selección de productos biotecnológicos
Carrito vacío
Agrega productos desde las secciones de arriba
